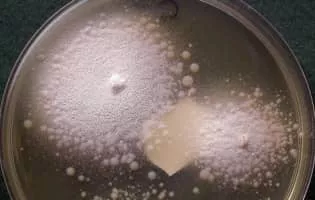
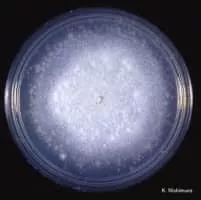

Conidiobolus
| Use attributes for filter ! | |
| Scientific name | Conidiobolus |
|---|---|
| Rank | Genus |
| Division | Entomophthoromycota |
| Higher classification | Ancylistaceae |
| Class | Entomophthoromycetes |
| Date of Reg. | |
| Date of Upd. | |
| ID | 2248363 |
About Conidiobolus
Conidiobolus is a genus of fungi. It is responsible for the condition conidiobolomycosis.